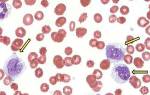

Что такое рак поджелудочной железы?
Рак поджелудочной железы
Рак поджелудочной железы — это злокачественное образование, возникающее в поджелудочной железе. Опухоль состоит из атипичных клеток, которые могут быть как железистого, так и плоского эпителия, выстилающего ацинарные элементы или протоки. Несмотря на достижения в диагностике и терапии онкологических заболеваний, рак поджелудочной железы остается одной из самых сложных проблем в онкологии. Это связано с анатомическими особенностями органа и быстрым развитием опухолевых процессов.
Согласно статистике, заболеваемость раком поджелудочной железы составляет от 9 до 11 случаев на 100 тысяч человек. Чаще всего это заболевание затрагивает людей среднего и пожилого возраста (от 40 до 75 лет), хотя встречаются случаи и у более молодых, и у пожилых пациентов. Мужчины страдают от этого заболевания почти в два раза чаще, чем женщины. Рак поджелудочной железы значительно чаще встречается в развитых странах Европы, Северной Америки, России и Канаде, чем в странах Африки, Южной Америки и Азии.
Частота поражения различных отделов поджелудочной железы варьируется. Более 90% случаев составляют опухоли, локализующиеся в головке органа, в то время как оставшиеся 10% распределены между телом и хвостом поджелудочной железы. Различные виды рака зависят от первичного клеточного субстрата опухоли и могут включать:
- Протоковая аденокарцинома (75-90% случаев);
- Гигантоклеточная аденокарцинома (около 6%);
- Железисто-плоскоклеточный рак (3-4%);
- Муцинозная аденокарцинома (1-3%);
- Редкие виды раковых опухолей поджелудочной железы: инсулома, глюкагонома, гастринома (не более 1% от общего числа).
Большинство случаев рака поджелудочной железы, независимо от типа клеток и места расположения опухоли, выявляются, когда их размер достигает 4-5 см. На этом этапе уже наблюдаются изменения в структуре органа, прорастание в важные анатомические образования, а также регионарное и отдаленное метастазирование.
Врачи отмечают, что рак поджелудочной железы является одной из самых агрессивных форм онкологических заболеваний. Основными причинами его развития считаются курение, ожирение, хронические панкреатиты и наследственная предрасположенность. Симптомы заболевания часто проявляются на поздних стадиях и могут включать необъяснимую потерю веса, желтуху, боли в верхней части живота и нарушение пищеварения. Врачи подчеркивают важность ранней диагностики, так как это значительно увеличивает шансы на успешное лечение. Основные методы терапии включают хирургическое вмешательство, химиотерапию и радиотерапию. Комплексный подход к лечению, включая поддержку со стороны специалистов, играет ключевую роль в повышении качества жизни пациентов.

Сколько живут люди с раком поджелудочной железы?
Данное заболевание относится к числу наиболее серьезных патологий, так как его ранняя диагностика представляет значительную сложность. Хирургические вмешательства и химиотерапия, используемые в радикальном онкологическом лечении, часто плохо переносятся пациентами из-за травматичности и агрессивного воздействия на организм. Эти факторы значительно снижают шансы на выживание. Средняя продолжительность жизни людей с диагностированным раком поджелудочной железы составляет от 6 месяцев до года. Лишь 1-5% пациентов преодолевают пятилетний рубеж.
Если болезнь выявляется на ранних стадиях, прогнозы становятся более оптимистичными, однако они в значительной степени зависят от своевременности лечения. Операции, из-за высокой сложности, часто заканчиваются летальным исходом как в ранний, так и в поздний послеоперационный период.
Эти печальные факты поднимают рак поджелудочной железы на особую ступень среди онкологических заболеваний. Ни один другой вид рака не имеет столь удручающей статистики. В последние годы наблюдается рост заболеваемости, при этом показатели ранней диагностики остаются крайне низкими. В 85-90% случаев болезнь выявляется на поздних стадиях, когда лечение становится невозможным. Ранняя диагностика затруднена длительным бессимптомным течением рака и его глубоким расположением в забрюшинной области, что делает его практически невидимым даже для современных методов обследования. Часто рак поджелудочной железы обнаруживается случайно во время диагностических процедур, проводимых по другим заболеваниям.
| Причина | Симптом | Лечение |
|---|---|---|
| Курение | Желтуха (пожелтение кожи и глаз) | Хирургическое вмешательство (панкреатодуоденэктомия, дистальная панкреатэктомия) |
| Хронический панкреатит | Боль в животе (часто в верхней части живота, может отдавать в спину) | Химиотерапия (например, FOLFIRINOX, gemcitabine) |
| Сахарный диабет | Ухудшение аппетита и потеря веса | Лучевая терапия |
| Наследственность (мутации генов BRCA1/2, CDKN2A, PALB2, MLH1, MSH2, MSH6, PMS2) | Тошнота и рвота | Таргетная терапия (например, ингибиторы PARP) |
| Ожирение | Изменение цвета стула (светлый, глинистый) | Паллиативная терапия (для облегчения симптомов) |
| Возраст (чаще встречается у людей старше 65 лет) | Запор | |
| Раса (чаще встречается у афроамериканцев) | Усталость | |
| Диета с низким содержанием фруктов и овощей |
Симптомы рака поджелудочной железы
Несмотря на неблагоприятные статистические данные по раку поджелудочной железы, не стоит опускать руки в борьбе с этой болезнью. Такой подход лишь приведет к безысходности. Ранняя диагностика может стать ключом к тому, чтобы попасть в 1-5% пациентов, которые переживают пять лет после постановки диагноза. Существуют случаи, когда люди живут более десяти лет после выявления рака поджелудочной железы.
Не стоит отчаиваться. Умеренная настороженность, не переходящая в манию, в сочетании с внимательностью к изменениям в организме помогут выявить заболевание на ранних стадиях и предпринять необходимые меры для борьбы с ним.
К симптомам рака поджелудочной железы относятся:
- Боль в верхней части живота и пояснице, а также в левом подреберье. Интенсивность боли может варьироваться. Появление этого симптома указывает на прогрессирование заболевания: чем сильнее боль, тем более запущена стадия болезни.
- Снижение аппетита. Этот симптом может проявляться уже на ранних стадиях и со временем усиливается.
- Признаки сахарного диабета: жажда, постоянная сухость во рту, увеличение объема мочи. В 15% случаев рак поджелудочной железы проявляется именно такими симптомами.
- Частые тромбофлебиты нижних конечностей. Иногда первым признаком рака поджелудочной железы становится стойкое или повторяющееся воспаление поверхностных вен на ногах без видимых причин (например, отсутствия варикоза, травм или других факторов риска).
- Увеличение объема живота. Этот симптом редко является первым признаком болезни, но в запущенных случаях он всегда присутствует. Его появление связано с метастазами в брюшной полости (канцероматоз) и накоплением асцитической жидкости.
Рак поджелудочной железы — одно из самых сложных и опасных заболеваний. Многие люди отмечают, что симптомы часто проявляются на поздних стадиях, что затрудняет диагностику. Основные признаки включают боль в животе, потерю аппетита, необъяснимую потерю веса и желтуху. Причины заболевания разнообразны: от генетической предрасположенности до вредных привычек, таких как курение и неправильное питание. Лечение рака поджелудочной железы может включать хирургическое вмешательство, химиотерапию и радиотерапию, однако успех терапии зависит от стадии заболевания. Важно помнить о регулярных медицинских осмотрах и внимательном отношении к своему здоровью, чтобы выявить болезнь на ранней стадии.

Первые признаки рака поджелудочной железы
К числу первых признаков болезни можно отнести:
- Вздутие и дискомфорт в области желудка (эпигастральная зона). Это один из самых ранних симптомов, наблюдаемый более чем у 30% пациентов.
- Общая слабость и недомогание без видимой причины — ещё один ранний признак, встречающийся в 25% случаев.
- Потеря веса без очевидных причин. Этот симптом отмечают 98% больных.
- Тошнота, сопровождающаяся периодической рвотой и другими нарушениями пищеварения. Данный симптом наблюдается в 45-50% случаев.
- Желтушность кожи. Это один из наиболее распространённых и характерных признаков болезни (в 65% случаев) при наличии опухоли в головке поджелудочной железы. Желтуха возникает из-за сжатия общего желчного протока, проходящего через ткани поджелудочной железы. Пожелтение кожи может проявиться даже при небольших размерах опухоли, когда она ещё не выходит за пределы органа. Однако в большинстве случаев желтуха указывает на тяжёлые формы рака.
[Видео] Доктор Берг — Первые симптомы рака поджелудочной железы:
Причины рака поджелудочной железы
Панкреатический рак — это заболевание с множественными причинами. Разнообразные факторы могут способствовать его развитию. Независимо от их природы, негативное воздействие на ткани поджелудочной железы приводит к повреждению клеточной ДНК. Это вызывает мутации в генах эпителиальных, железистых или эндокринных клеток, отвечающих за апоптоз (программированную гибель). В результате клетки начинают проявлять аномальные свойства, теряют свои функции и бесконтрольно размножаются.
Факторы, способные инициировать мутации в генетическом материале клеток, включают:
- Хронический панкреатит. У большинства пациентов с раком поджелудочной железы в анамнезе присутствует это заболевание. Длительное воспаление приводит к образованию свободных радикалов и других продуктов перекисного окисления липидов, которые накапливаются в тканях и могут повреждать генетический материал поджелудочной железы.
- Генетическая предрасположенность. Врождённые мутации генов р53 и K-ras также играют роль.
- Курение. Существует связь между активным курением и повышенной частотой раковых трансформаций панкреатических клеток.
- Питание. Длительное преобладание мясной пищи в рационе отмечается у около 80% пациентов.
- Онкогенные вирусы. Их роль в возникновении мутаций пока не установлена и находится на стадии исследования.
- Канцерогены. Химические и физические канцерогены могут попадать в организм через воздух, пищу и воду. К ним относятся пестициды, гербициды, компоненты бытовой химии, производные бензидина, ионизирующая радиация и соли тяжёлых металлов.
- Алкоголь. Прямой связи между раком поджелудочной железы и злоупотреблением алкоголем не установлено. Однако алкоголь является одним из основных факторов риска хронического панкреатита, что делает его влияние на развитие раковых заболеваний поджелудочной железы обоснованным.
Интересный факт. Исследования показывают, что у 95% пациентов с раком поджелудочной железы в желудке обнаруживается Helicobacter pylori. На данный момент доказана лишь её связь с язвенной болезнью двенадцатиперстной кишки. Тем не менее, многие ведущие медицинские учреждения продолжают изучать эту тему. Остаётся надеяться, что дальнейшие исследования помогут выяснить, может ли этот микроорганизм вызывать повреждение ДНК клеток поджелудочной железы.

Степени рака поджелудочной железы
Классификация рака поджелудочной железы по стадиям имеет важное значение. Эти данные необходимы для разработки стратегии и плана лечения. Необходимо различать термин «стадия онкологического заболевания» и понятие «клиническая группа» болезни. Первая категория описывает степень поражения и распространённость опухоли, в то время как вторая указывает на реакцию пациента на лечение. Рассмотрим стадии заболевания, которые делятся на четыре уровня.
1 степень
С анатомической и клинической точки зрения первую стадию рака поджелудочной железы можно разделить на три категории:
- 0 (нулевая) стадия. В медицинской терминологии это называется carcinoma in situ. На этой стадии опухоль остается в пределах базальной мембраны клеточного слоя, из которого она формируется. Она не вызывает симптомов и изменений в структуре органа и не имеет способности к метастазированию.
- 1А стадия. Опухоль проникает через базальную мембрану и достигает размера 2 см.
- 1Б стадия. Размер опухоли превышает 2 см, однако она остается внутри органа, не прорастает в важные анатомические структуры и не имеет метастазов.
2 степень
Второй этап рака поджелудочной железы характеризуется распространением опухоли за пределы органа. На этой стадии выделяют следующие подкатегории:
- 2А – опухоль проникает в важные анатомические структуры, такие как холедох, двенадцатиперстная кишка, мезентериальные сосуды, клетчатка и связки. Метастазы отсутствуют;
- 2Б – опухоль может выходить за пределы поджелудочной железы или оставаться в её толще, но при этом уже имеются метастазы в лимфатические узлы первого порядка, находящиеся вне органа.
3 степень
На этой стадии происходит метастатическое распространение раковой опухоли на регионарные лимфатические узлы второго и третьего порядка. Метастазы могут обнаруживаться в парааортальных и забрюшинных лимфатических узлах, а также вдоль верхней брыжеечной, воротной и общей печеночной артерий и вен. При этом первичная опухоль значительно выходит за пределы органа, прорастая в желудок, двенадцатиперстную кишку и окружающие сосуды.
4 степень
Четвёртая стадия рака, включая рак поджелудочной железы, считается самой тяжёлой и безнадёжной. Она характеризуется обширным распространением первичной опухоли на соседние органы и метастазированием в лимфатические узлы. Ключевым признаком этой стадии являются метастазы, которые могут поражать удалённые органы, такие как печень и лёгкие.
Диагностика рака поджелудочной железы
Заподозрить и подтвердить наличие рака поджелудочной железы может быть непросто, особенно на ранних стадиях, когда опухоль достигает всего 1-2 см.
Для диагностики применяются следующие методы:
- Ультразвуковое исследование. Этот метод включает осмотр органов брюшной полости и забрюшинного пространства с акцентом на поджелудочную железу. Информативность УЗИ зависит от соблюдения правил подготовки, так как орган находится на значительной глубине и его сложно исследовать из-за газов в поперечной ободочной кишке.
- Томографическое исследование. Включает компьютерную и магнитно-резонансную томографию (КТ и МРТ). Рекомендуется отдавать предпочтение МРТ, так как этот метод лучше визуализирует мягкие ткани, включая поджелудочную железу. Он стал золотым стандартом для диагностики рака на ранних стадиях и позволяет выявить метастазы в регионарных лимфатических узлах и других органах.
- Анализ крови на онкомаркеры. Этот метод основан на определении в крови концентрации специфических белков и антигенов, вырабатываемых опухолями поджелудочной железы. Основные онкомаркеры — СА 19-9 и СЕА (раковый эмбриональный антиген). Нормативные значения устанавливаются конкретной лабораторией в зависимости от используемых реактивов и обязательно указываются рядом с результатами анализа.
- ЭРХПГ — эндоскопическая ретроградная холангиопанкреатография. Этот метод не подтверждает диагноз рака поджелудочной железы, но используется для исключения камней в желчных протоках, которые могут вызывать механическую желтуху, один из основных симптомов рака в головке органа.
- Биопсия поджелудочной железы. Наиболее надежным способом подтверждения диагноза является гистологическое исследование измененного участка. Проведение биопсии связано с определенными рисками и техническими сложностями. Этот метод осуществляется под визуальным контролем. Процесс введения тонкой иглы, прокалывающей ткани, контролируется с помощью МРТ, ультразвукового аппарата или в ходе диагностической лапароскопической операции, которая считается наиболее предпочтительной.
Рак поджелудочной железы с метастазами
Злокачественные опухоли поджелудочной железы характеризуются ранним метастазированием. Это связано с интенсивным кровоснабжением органа и наличием большого количества лимфатических сосудов и лимфоузлов.
Даже небольшие опухоли, особенно высокодифференцированные аденокарциномы, могут метастазировать по следующим путям:
- Лимфогенному – в регионарные лимфатические узлы вдоль крупных артерий, забрюшинной клетчатки и ворот печени;
- Гематогенному – в печень, легкие, кости и позвоночник;
- Смешанному (сочетание гематогенного, лимфогенного и контактного путей) – в брюшину, кишечник, желудок и другие органы брюшной полости.
Наиболее распространёнными являются отдалённые метастазы в печень. Они прогрессируют, проявляясь новыми очагами, которые постоянно увеличиваются в размерах. На четвёртой стадии заболевания печень у таких пациентов значительно увеличивается и принимает форму опухолевого конгломерата, состоящего из множества метастатических узлов.
Вторым по частоте местом отдалённых метастазов является брюшина, что называется канцероматозом. Метастазы этого типа также имеют тенденцию к постоянному увеличению как в количестве, так и в размерах на месте прикрепления. При этом всегда наблюдается асцит, возникающий из-за раздражения брюшины, что приводит к увеличению секреции внутрибрюшной жидкости и нарушению её всасывания.
Наличие метастазов при раке поджелудочной железы значительно ухудшает течение заболевания и делает лечение практически безнадёжным, так как оно не приносит ожидаемых результатов. Метастазы, подобно первичной опухоли, требуют значительных ресурсов организма для своего роста. На этом фоне наблюдается прогрессивное снижение уровня белка и гемоглобина в крови, ухудшение иммунной системы и развитие выраженной раковой интоксикации, что приводит к кахексии пациента.
Лечение рака поджелудочной железы
Комплексный подход к лечению рака поджелудочной железы включает несколько ключевых методов:
-
Хирургическое вмешательство. Операбельными считаются опухоли на 1-2 стадии, а в некоторых случаях и на 3 стадии, когда возможно удалить новообразование, а состояние пациента позволяет перенести такую серьезную операцию.
В числе проводимых операций выделяются:
- Панкреатодуоденальная резекция (ПДР) в классическом исполнении. Этот метод применяется при раке, локализующемся в головке и близлежащих участках тела поджелудочной железы. В процессе операции выполняется лимфодиссекция регионарных лимфатических узлов. Удаляются головка и тело поджелудочной железы, двенадцатиперстная кишка, часть холедоха и желудка. После удаления всего блока с лимфоузлами восстанавливается проходимость желудочно-кишечного тракта с помощью анастомоза. К отключенной по Ру петле тонкой кишки подшиваются холедох и панкреатический проток. Эта операция высокотравматична и может сопровождаться множеством осложнений и высокой летальностью;
- Резекция хвоста поджелудочной железы. Это менее сложная операция по сравнению с ПДР, которая проводится при наличии опухоли в хвосте органа. В ходе вмешательства удаляется дистальная часть поджелудочной железы, а также селезёнка и лимфатические узлы;
- Панкреатэктомия и расширенная резекция поджелудочной железы. Панкреатэктомия выполняется крайне редко, тогда как расширенная резекция может включать как ПДР, так и резекцию хвоста в сочетании с удалением других органов, если они поражены опухолью.
-
Химиотерапия. Этот метод включает введение препаратов, обладающих токсическим воздействием на опухолевые клетки. Химиотерапия часто применяется в комбинации с хирургическим лечением или используется как самостоятельный метод при неоперабельных формах рака.
-
Лучевая терапия. Данный метод используется крайне редко в лечении рака поджелудочной железы. Он предполагает целенаправленное введение высоких доз ионизирующего излучения непосредственно к опухоли через кожу.
-
Паллиативное и симптоматическое лечение. Включает хирургические вмешательства, направленные на восстановление проходимости желудка, двенадцатиперстной кишки и желчных путей, без манипуляций с самой опухолью. Симптоматическая терапия включает применение обезболивающих и детоксикационных средств.
Питание при раке поджелудочной железы
Питание при раке поджелудочной железы часто недооценивается, хотя правильная диета может помочь минимизировать неприятные симптомы, связанные с расстройствами пищеварения. Пища должна быть щадящей, чтобы не усугублять состояние поджелудочной железы, и в то же время питательной, чтобы удовлетворять потребности организма в необходимых веществах.
Достичь такого баланса можно, следуя рекомендациям, представленным в таблице:
| Тип продуктов | Разрешенные | Запрещенные |
| Мясные и рыбные блюда | Диетические сорта мяса (индейка, кролик, курица) и нежирная морская или речная рыба, приготовленная на пару. | Жирные сорта мяса (свинина, говядина, утка, гусь) и жирная рыба. Запрещены жареные, копченые и острые блюда. |
| Мучные и хлебобулочные изделия | Хлеб с отрубями и мукой грубого помола, галетное и овсяное печенье. Выпечка должна быть не слишком свежей. | Сдобные изделия, сладкая выпечка с кремами и шоколадом (булочки, печенье, трубочки). |
| Молочная продукция | Простокваша, кефир, ряженка, йогурт, нежирный творог, плавленый и твердый сыр. | Цельное молоко и жирная сметана. |
| Овощи и фрукты | Свежие овощные и фруктовые салаты, если они не вызывают вздутия или поноса. Салаты можно заправлять растительными маслами (оливковое, подсолнечное), йогуртом или джемом. Овощи можно добавлять в супы и бульоны, готовить на пару. | Кислые овощи и фрукты, ограничение на томаты и сырую капусту (предпочтительнее тушеная). Если какие-либо продукты ухудшают состояние, их следует исключить. |
| Крупы | Рисовая, гречневая, перловая, овсяная каша и пшено. | Бобовые и блюда на основе гороха. |
| Прочее | Яйца всмятку, мед, орехи, небольшое количество подсолнечного масла, морсы, чай, отвар из сухофруктов и компот. | Шоколад, кофе, пряности, грибы, алкогольные напитки, газированная вода с красителями. Употребление соли и сахара должно быть ограничено. |
Питание пациента с раком поджелудочной железы должно основываться на переносимости конкретных продуктов. Если возникает желание съесть что-то, что не входит в список разрешенных, стоит учитывать предпочтения пациента. Главное правило — постепенное введение новых продуктов в рацион!
Интересный факт: Тимокинон, активное вещество семян черного тмина, может уменьшить размер опухоли поджелудочной железы в среднем на 67% и значительно снижает уровень цитокинов в опухолях, обладая мощным противовоспалительным эффектом. Эти исследования проводились на животных с раком поджелудочной железы в центре Киммела (США).
По теме: полезные свойства и применение масла черного тмина.
Примерное меню на неделю для пациента с раком поджелудочной железы при пятиразовом питании представлено в таблице:
| День недели | Первый прием пищи | Второй прием пищи | Третий прием пищи | Четвертый прием пищи | Пятый прием пищи |
| Пн. | Кефир и банан | Суп-пюре, чай с хлебом и маслом | Каша с отварной котлетой, овощной салат, компот | Творожная запеканка с какао | Сухари с йогуртом |
| Вт. | Молочная каша с маслом | Фаршированный перец, травяной чай | Суп с крупами на курином бульоне, хлеб | Фруктово-творожная запеканка, какао | Кефир с сухарями |
| Ср. | Кефир, овсяное печенье | Паровые рыбные котлеты, рисовая каша | Борщ, овощной салат, компот | Запеченные яблоки с киселем | Ряженка с галетным печеньем |
| Чт. | Йогурт с галетным печеньем | Гречневая каша, овощной салат, зеленый чай | Картофельное пюре с паровой котлетой, хлеб, кисель | Морковный сок, яичный омлет | Узвар из сухофруктов с медом |
| Пт. | Запеченное яблоко, зеленый чай | Овощной суп, хлеб с отрубями | Ячневая каша с маслом, отварная рыба, овощной салат, компот | Свежие фрукты, некрепкий чай | Кефир с сухарями |
| Сб. | Творожная запеканка, какао | Крем-суп из овощей и мяса кролика | Макароны с маслом и докторской колбасой, хлеб, компот | Молочная каша с фруктовым вареньем | Стакан кефира |
| Вс. | Йогурт с галетным печеньем или сухарями | Крем-суп из картофеля, цветной капусты и куриного фарша | Рыбное филе с отварными овощами, узвар из сухофруктов | Банан с творогом | Йогурт с овсяным печеньем |
Данное меню не является строгим стандартом и может быть адаптировано в зависимости от предпочтений пациента. Количество приемов пищи можно увеличить до шести и более раз в день, если пациент предпочитает есть небольшими порциями.
Вопрос-ответ
Каковы первые признаки и симптомы рака поджелудочной железы?
Боль в животе либо спине, потеря веса, желтизна кожи и/или глаз с зудом или без него, потеря аппетита, тошнота, изменение стула, панкреатит и резко возникший диабет — это симптомы, которые могут указывать на рак поджелудочной железы.
Что является причиной рака поджелудочной железы?
В качестве фактора риска выделяют курение – у 1-2% курильщиков развивается рак поджелудочной железы. Специалисты признают, что табакокурение удваивает риск развития рака поджелудочной железы. Кроме того, одним из основных факторов, предрасполагающих к развитию панкреатического рака, является сахарный диабет.
Каковы симптомы рака поджелудочной железы?
Симптомы рака поджелудочной железы могут включать необъяснимую потерю веса, желтуху (пожелтение кожи и глаз), боли в животе или спине, потерю аппетита, тошноту и изменение стула (например, светлый или жирный стул). На ранних стадиях заболевание может протекать бессимптомно, что затрудняет его раннюю диагностику.
Что можно спутать с раком поджелудочной железы?
Рак поджелудочной железы маскируется под сахарный диабет, болезни жёлчного пузыря, язвенную болезнь желудка.
Советы
СОВЕТ №1
Регулярно проходите медицинские обследования, особенно если у вас есть предрасположенность к заболеваниям поджелудочной железы. Раннее выявление рака может значительно повысить шансы на успешное лечение.
СОВЕТ №2
Обратите внимание на свое питание. Употребление большого количества фруктов, овощей и цельнозерновых продуктов может помочь снизить риск развития рака поджелудочной железы. Избегайте избыточного потребления красного мяса и обработанных продуктов.
СОВЕТ №3
Следите за своим весом и уровнем физической активности. Избыточный вес и малоподвижный образ жизни могут увеличить риск развития рака поджелудочной железы. Регулярные физические нагрузки помогут поддерживать здоровье и снизить риск заболеваний.
СОВЕТ №4
Обратите внимание на симптомы, такие как необъяснимая потеря веса, желтуха, боли в животе или спине. Если вы заметили что-либо из этого, немедленно обратитесь к врачу для обследования.